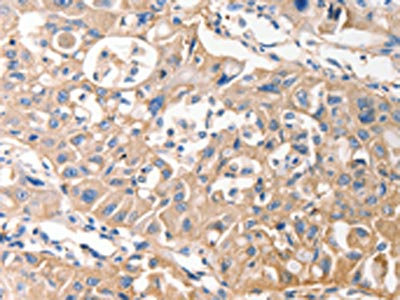

MVP Antibody
-
中文名稱:MVP兔多克隆抗體
-
貨號:CSB-PA018595
-
規(guī)格:¥1100
-
圖片:
-
The image on the left is immunohistochemistry of paraffin-embedded Human lung cancer tissue using CSB-PA018595(MVP Antibody) at dilution 1/40, on the right is treated with fusion protein. (Original magnification: ×200)
-
The image on the left is immunohistochemistry of paraffin-embedded Human esophagus cancer tissue using CSB-PA018595(MVP Antibody) at dilution 1/40, on the right is treated with fusion protein. (Original magnification: ×200)
-
Gel: 8%SDS-PAGE, Lysate: 50 μg, Lane 1-2: 231 cells, mouse kidney tissue, Primary antibody: CSB-PA018595(MVP Antibody) at dilution 1/500, Secondary antibody: Goat anti rabbit IgG at 1/8000 dilution, Exposure time: 1 second
-
-
其他:
產(chǎn)品詳情
-
Uniprot No.:
-
基因名:MVP
-
別名:LRP antibody; Lung resistance related protein antibody; Lung resistance-related protein antibody; Major vault protein antibody; Major vault protein; rat; homolog of antibody; MVP antibody; MVP_HUMAN antibody; testicular secretory protein Li 30 antibody; VAULT 1 antibody; VAULT1 antibody
-
宿主:Rabbit
-
反應(yīng)種屬:Human,Mouse,Rat
-
免疫原:Fusion protein of Human MVP
-
免疫原種屬:Homo sapiens (Human)
-
標(biāo)記方式:Non-conjugated
-
抗體亞型:IgG
-
純化方式:Antigen affinity purification
-
濃度:It differs from different batches. Please contact us to confirm it.
-
保存緩沖液:-20°C, pH7.4 PBS, 0.05% NaN3, 40% Glycerol
-
產(chǎn)品提供形式:Liquid
-
應(yīng)用范圍:ELISA,WB,IHC
-
推薦稀釋比:
Application Recommended Dilution ELISA 1:2000-1:5000 WB 1:500-1:2000 IHC 1:25-1:100 -
Protocols:
-
儲存條件:Upon receipt, store at -20°C or -80°C. Avoid repeated freeze.
-
貨期:Basically, we can dispatch the products out in 1-3 working days after receiving your orders. Delivery time maybe differs from different purchasing way or location, please kindly consult your local distributors for specific delivery time.
-
用途:For Research Use Only. Not for use in diagnostic or therapeutic procedures.
相關(guān)產(chǎn)品
靶點詳情
-
功能:Required for normal vault structure. Vaults are multi-subunit structures that may act as scaffolds for proteins involved in signal transduction. Vaults may also play a role in nucleo-cytoplasmic transport. Down-regulates IFNG-mediated STAT1 signaling and subsequent activation of JAK. Down-regulates SRC activity and signaling through MAP kinases.
-
基因功能參考文獻:
- KPNA7 binding and nuclear transfer was validated for two proteins, MVP and ZNF414. MVP and ZNF414 have a key role in the regulation of pancreatic cancer cell growth. PMID: 27664836
- Knockout of MVP leads to miR-193a accumulation in the exosomal donor cells instead of exosomes, inhibiting tumour progression. PMID: 28211508
- The expression levels of LRP and GSTP1 in primary epithelial ovarian cancer were the highest, followed by borderline adenoma tissues, and lowest levels in benign tumor tissues. The difference between resistant gene negative-expression and positive-expression of chemotherapy efficiency, disease free survival time, and recurrence time were statistically significant. PMID: 30313031
- KIF4A promotes drug resistance of lung adenocarcinoma cells through transporting LRP-based vaults along microtubules towards the cell membrane PMID: 29204984
- Major vault protein is important in the drug resistance of cancer cells, but it requires the presence of vPARP for full activity PMID: 28551640
- involved in doxorubicin resistance of non-small cell lung cancer PMID: 27817195
- Study found significant upregulation of MVP and BCRP whereas MRP1 and UGT1A4 were unaltered in drug resistant epilepsy brains. While upregulation of BCRP was significantly higher in mesial temporal lobe epilepsy (9.34+/-0.45; p<0.05), upregulation of MVP was significantly higher in focal cortical dysplasia (2.94+/-0.65; p<0.01). PMID: 28273590
- Taxus chinensis var.-mediated downregulation of MRP1, MDR1, and LRP might contribute to the reversal of drug resistance in non-small cell lung cancer stem cells. PMID: 27706681
- We believe that for the first time, genetic variants at XRCC6 and MVP genes are associated with risk of more aggressive disease, and would be taken into account when assessing the malignancy of prostate cancer PMID: 26754263
- MVP genetic polymorphisms and haplotypes may not be associated with drug resistance of partial epilepsy in the Chinese Han population. PMID: 26476776
- NSCLCs [ non-small cell lung cancer ] expressing P-gp [P-glycoprotein ]/LRP [ lung resistance-related protein] bear the EGFR [epidermal growth factor receptor] mutation in exon 19 or 21 easily. PMID: 26632382
- The association of MVP amplification and PTEN deletion could be a potential biomarker in glioblastoma. PMID: 25869624
- Bag3-MVP is an important complex that regulates a potent prosurvival signaling pathway and contributes to chemotherapy resistance in breast cancer PMID: 24997994
- LDL increases ABCB1, ABCC1, and LRP expression in a human doxorubicin-resistant uterine sarcoma cell line. PMID: 25603048
- Study demonstrates that vaults have a tumour-promoting potential by stabilizing EGFR/PI3K-mediated migration and survival pathways in human glioblastoma. PMID: 24243798
- USF1 binding to an E-box element may be critical for basal MVP promoter activation. PMID: 24173679
- hyperosmotic stress upregulates Sp1 expression levels by inhibiting ubiquitination through the activation of JNK, and the induction of Sp1 expression directly enhances MVP transcription. PMID: 23820674
- the protein levels of MVP, TEP1 and vPARP are actually increased in the highergrade tumors suggesting existence of post-transcriptional regulation of vault component production. PMID: 23739867
- Lung resistance-related protein is associated with malignant ascitic cells and recurrence in ovarian serous carcinoma. PMID: 23525731
- The phosphorylation-dependent binding between 14-3-3epsilon and MVP inhibits the drug-resistant activity of MVP. PMID: 23590642
- rs4788187, rs3815824, rs3815823 variants of the MVP gene are associated neither with predisposition for epilepsy nor with AED-resistance in the population that we have studied. PMID: 23751308
- MVP and IGF-1R expression are related in oral squamous cell carcinoma and conferred reduced long-term survival in patients suffering from advanced stages of the disease PMID: 22931894
- TRAIL may reduce the expression of drug-resistant genes MDR1, LRP and GST-pi, thereby participating in the reversion of the multidrug resistance of gastric cancer. PMID: 23178631
- GSTP1 and LRP have different effects on multi-drug resistance in adult acute leukemia. PMID: 22391170
- results suggest that the high expression of LRP in patients with tongue carcinoma indicates that intrinsic drug resistance may exist in tongue carcinoma, and is associated with tumor differentiation and cisplatin resistance in tongue carcinoma. PMID: 21793937
- These findings suggest MVP as a novel player in resistance against EGFR inhibition. PMID: 22261339
- MVP (major vault protein) expression increases dramatically in tissue samples from the frontal cortex of patients with surgically treated refractory epilepsy patients compared to histologically normal frontal lobe samples from controls. PMID: 21683962
- LRP and MRP play a role in multidrug resistance in non-small cell lung cancer (NSCLC) and are related to prognosis in patients with NSCLC PMID: 22117969
- Histopathology demonstrated increased amount of MVP/LRP proteins in cancer and showed translocation possibility between cytoplasm and nuclear envelope, which can be crucial in the prevention of nucleus against anticancer drugs. [review] PMID: 22235652
- MVP is hijacked by L. monocytogenes in order to counteract the autophagy process, a finding that could have major implications in deciphering the cellular role of vault particles. PMID: 21829365
- Loss of p53-related suppression of lung resistance-related protein through Y-box binding protein 1 may be the reason for LRP expression increase, and, therefore, chemotherapy resistance in tumor cells. PMID: 21344396
- The nasopharyngeal carcinoma patients with positive LRP and TS expression may be less sensitive to chemotherapy with DDP + 5-FU. PMID: 15952572
- Patients expressing both lung resistance protein and multidrug resistance-related protein genes had poorer outcomes and had worse 2-year survivalts. PMID: 19969624
- mRNA expression predicts chemotherapy response and survival in patients with non-small cell lung cancer who received neoadjuvant cisplatin-based chemotherapy PMID: 19875192
- P-gp and LRP expressions but not MRP expression are important in the mechanism of drug resistance associated with a poor clinical outcome in previously untreated non-Hodgkin's lymphoma. PMID: 19615260
- Data show that major vault protein (MVP), a lung resistance associated protein, is a binding partner of YPEL4. PMID: 20555386
- The expression of EGFR and LRP could be used to predict chemotherapy resistance and prognosis of ovarian cancer. PMID: 19080004
- findings suggest that Tax-related drug resistance of ATL cells is due to LRP and not MDR1, as reported previously. PMID: 11937269
- relationship between the expression of lung resistance-related protein (lrp) gene or multidrug resistance-associated protein (mrp) gene and prognosis in untreated acute leukemia (AL) patients PMID: 11940320
- LRP/MVP mRNA expression decreased as AML disease evolved, suggesting it is not associated with clinical resistant disease in AML. PMID: 11986944
- identification as a dominant PTEN-binding protein in a yeast two-hybrid screen PMID: 12177006
- RNA expression of this protein in breast cancer correlates with response to chemotherapy. PMID: 12576456
- expression of lung resistance-related protein in differentiated cells and subsequent expression after chemotherapy suggests that it plays a role in therapy-induced differentiation PMID: 12612883
- neither the presence nor the degree of immunoreactivity to MVP/LRP showed any correlation with either tumor grade or the presence of brain invasion PMID: 12622134
- In gangliogliomas, western blot analysis showed a consistent increase in major vault protein expression compared with control cortex. PMID: 12919388
- MVP and BCRP were expressed ubiquitously in brain capillary endothelium. Ectopic upregulation of MVP was seen in hilar neurons in HS, dysplastic neurons in FCD, and lesional neurons in DNT. Only in HS cases were rare extralesional neurons immunoreactive. PMID: 14636345
- Results suggest that major vault protein functions as a novel scaffold protein for both SHP-2 and Erk. PMID: 15133037
- The inverted MED1 element and the LRP130 protein have a role in transcription of the MVP gene. PMID: 15272088
- Expression of LRP tended to be down-regulated in carcinomas. Moreover, the expression of LRP inversely correlated with tumor grades. PMID: 15379935
- Vaults play no direct role in the multiple drug resistance phenotype in non-small cell lung carcinoma cells; their cellular function remains unknown. PMID: 15709737
顯示更多
收起更多
-
亞細胞定位:Cytoplasm. Nucleus, nuclear pore complex. Cytoplasm, perinuclear region. Note=5% found in the nuclear pore complex (PubMed:15133037). Translocates from the nucleus to the cytoplasm upon EGF treatment (PubMed:16441665).
-
組織特異性:Present in most normal tissues. Higher expression observed in epithelial cells with secretory and excretory functions, as well as in cells chronically exposed to xenobiotics, such as bronchial cells and cells lining the intestine. Overexpressed in many mu
-
數(shù)據(jù)庫鏈接:
Most popular with customers
-
YWHAB Recombinant Monoclonal Antibody
Applications: ELISA, WB, IHC, IF, FC
Species Reactivity: Human, Mouse, Rat
-
Phospho-YAP1 (S127) Recombinant Monoclonal Antibody
Applications: ELISA, WB, IHC
Species Reactivity: Human
-
-
-
-
-
-